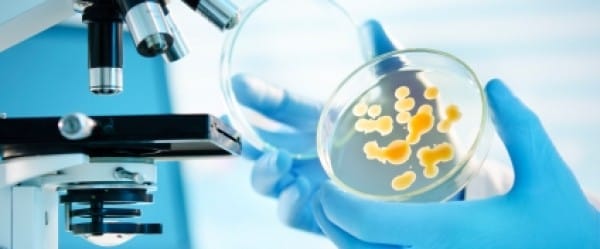
Vos champignons à vous

C’est déjà peu ragoûtant d’étudier les microbes en nous, voilà que d’autres chercheurs s’attaquent aux... champignons en nous.
Rien à voir avec l’hygiène ou l’alimentation : nous sommes peuplés de champignons, et souvent, c’est pour notre plus grand bien. Pas toujours toutefois, comme en témoignent ces biologistes qui, dans l’édition du 8 juin de Science, ont associé des champignons intestinaux à une inflammation du côlon. Sauf que leur étude a suscité un intérêt loin au-delà des spécialistes du côlon.
Parce qu’au cours des dernières années, il s’est développé un tel intérêt pour l’analyse de notre population microbienne qu’une nouvelle discipline scientifique est en train de naître : le microbiome, ou analyse des gènes de nos microbes — ils sont 10 fois plus nombreux que nos propres gènes.
Ne restait qu’à y ajouter les champignons pour obtenir un portrait complet de tout ce qui grouille là-dedans.